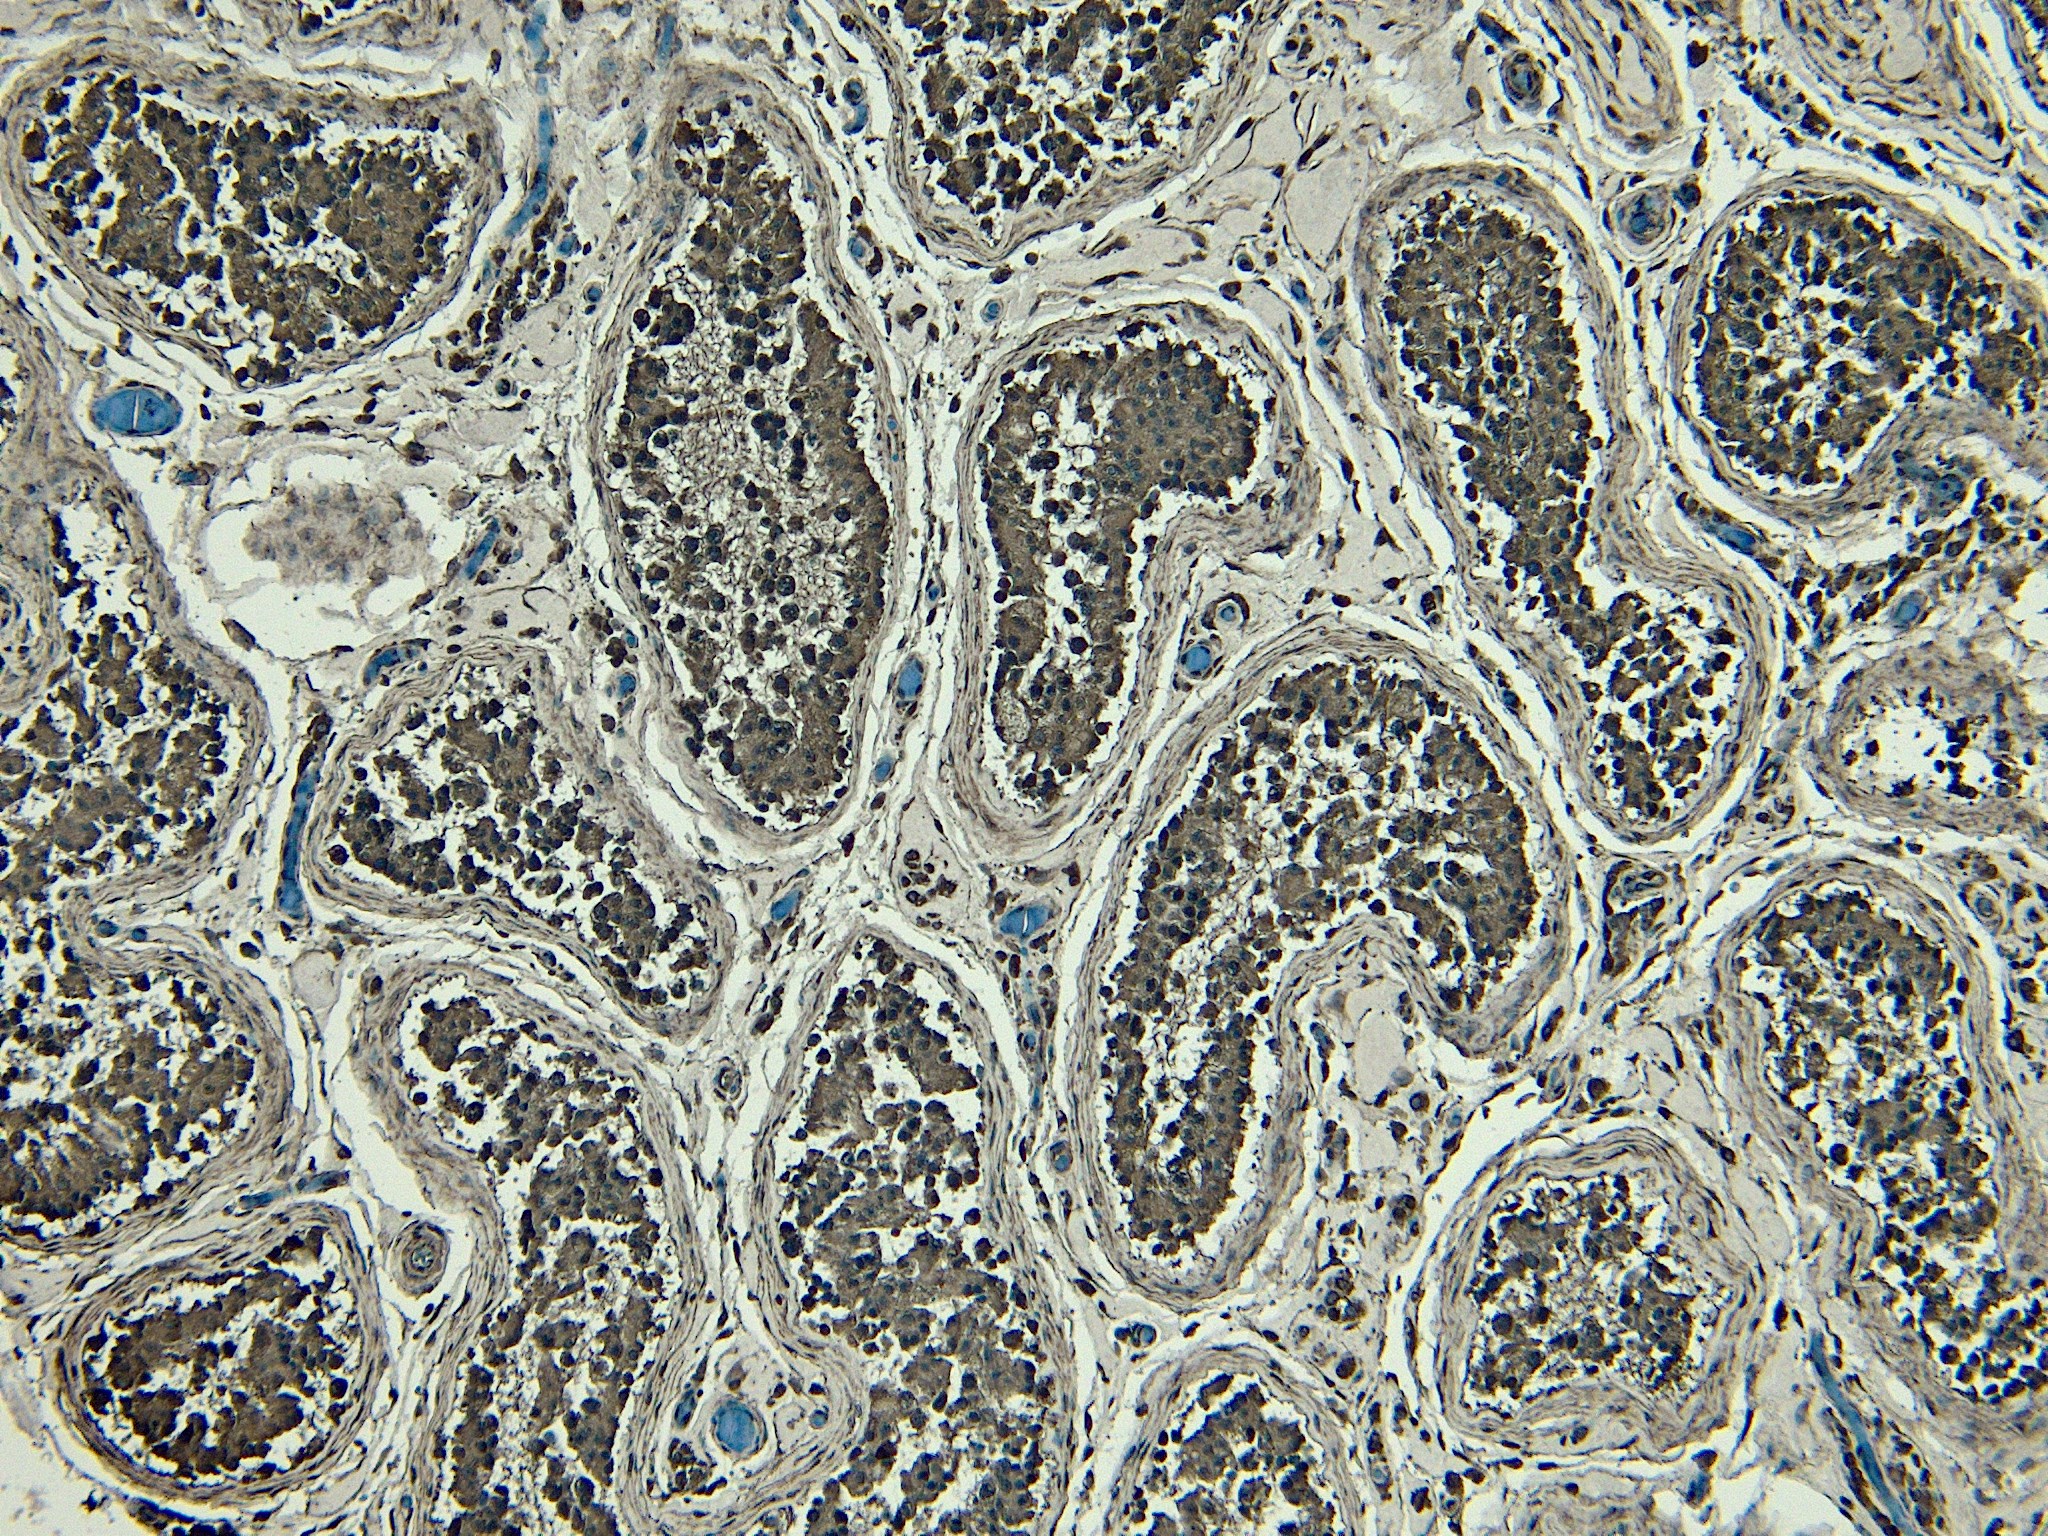

Formulation Supplied at 0.5 mg/ml in Tris saline, 0.02% sodium azide, pH7.3 with 0.5% bovine serum albumin.
| |
Unit Size 100 µg | |
Storage Instructions Aliquot and store at -20°C. Minimize freezing and thawing. | |
Synonym / Alias Names positive regulatory domain I-binding factor 1|beta-interferon gene positive-regulatory domain I binding factor|PRDI-binding factor-1|PR-domain zinc finger protein 1|OTTHUMP00000016918|B-lymphocyte-induced maturation protein 1|PRDI-BF1|MGC118925|MGC118924|MGC118923|MGC118922|BLIMP1|PR domain containing 1, with ZNF domain|PRDM1 | |
Usage Summary Immunofluorescence: Strong expression of the protein seen in the nuclei of HeLa cells. Recommended concentration: 10µg/ml.
Flow Cytometry: Flow cytometric analysis of A431 cells. Recommended concentration: 10ug/ml. | |
Accession ID NP_001189.2; NP_878911.1 | |
Blocking Peptide EBP09715 | |
Immunogen Peptide with sequence C-DISDNADRLEDVED, from the internal region of the protein sequence according to NP_001189.2; NP_878911.1. | |
Product Comments This antibody is expected to recognize both reported isoforms (NP_001189.2; NP_878911.1). | |
Peptide Sequence C-DISDNADRLEDVED | |
Purification Method Purified from goat serum by ammonium sulphate precipitation followed by antigen affinity chromatography using the immunizing peptide. | |
Shipping Instructions Refrigerated | |
Predicted Species Human, Mouse, Rat, Dog, Cow, Pig | |
Reactive Species Human | |
Human Gene ID 639 | |
Mouse Gene ID 12142 | |
Rat Gene ID 309871 | |
Product Grade  | |
IHC Results Paraffin embedded Human Testis. Recommended concentration: 6µg/ml. | |
ELISA Detection Limit Antibody detection limit dilution 1:1000. | |
Western Blot Approx 90kDa band observed in lysates of cell lines A431 and Nuclear K562, and approx. 100kDa in lysates of cell line K562. An additional faint band of approx 70kDa was also seen in some A431 and K562 lysates (calculated MW of 91.8kDa according to NP_001189.2 isoform 1 and 76.8kD according to NP_878911.1 isoform 2). Recommended concentration: 0.1-2g/ml. Primary incubation 1 hour at room temperature. | |
Application Type Pep-ELISA, WB, IHC, IF, FC |
Goat Anti-PRDM1 / MEL1 Antibody
$431.00
| SKU | Unit Size | Price |
|---|---|---|
Select a unit size:
Documents |